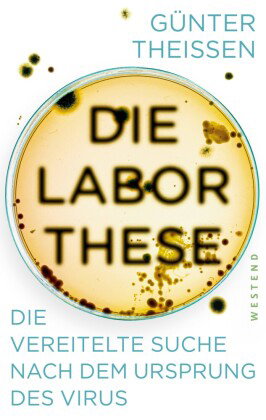
Das Virus

Diese Website verwendet Cookies und ähnliche Technologien. Dabei handelt es sich um kleine Textdateien, die auf eurem Computer gespeichert und ausgelesen werden. Indem ihr auf "Alles akzeptieren" klickt, stimmt ihr der Verarbeitung von Daten, der Erstellung und Verarbeitung von individuellen Nutzungsprofilen über Websites und über Partner und Geräte hinweg sowie der Übermittlung eurer Daten an Drittanbieter zu, die eure Daten teilweise in Ländern außerhalb der Europäischen Union verarbeiten (GDPR Art. 49). Einzelheiten hierzu findet ihr in den Datenschutzhinweisen. Die Daten werden für Analysen und für eigene Zwecke Dritter verwendet. Weitere Informationen, auch über die Datenverarbeitung durch Drittanbieter und die Möglichkeit des Widerrufs, findet ihr in den Einstellungen und in unseren Datenschutzhinweisen. Hier könnt ihr mit den notwendigen Tools fortfahren.
- Verlag: Westend
- Autor: Günter Theißen
- Artikel-Nr.: KNV95608759
- ISBN: 9783864893728